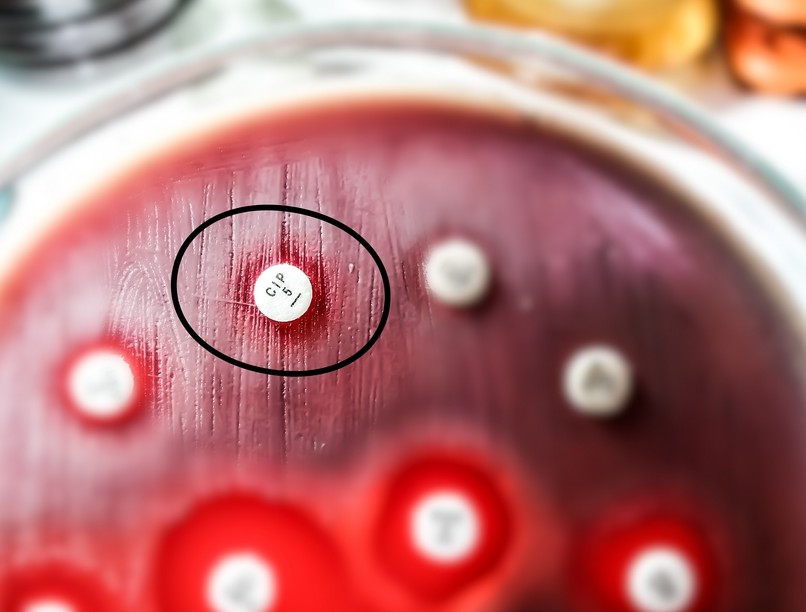
hatástalan antibiotikum baktériumok kezelése

Aggasztó felfedezést tettek az antibiotikumok jövőjével kapcsolatban a HUN-REN Szegedi Biológiai Kutatóközpont kutatói.
Kimutatták, hogy a legveszélyesebb kórházi fertőzéseket okozó baktériumok képesek ellenállóvá (rezisztenssé) válni olyan új antibiotikumok ellen, amik még nem kerültek piacra. Emiatt ezek a fontos gyógyszerek azelőtt elveszíthetik a hatékonyságukat, hogy széleskörű használatuk megkezdődne. Mindezen eredményeiket a napokban a Science Translational Medicine és a Nature Microbiology tudományos folyóiratokban közölték le.
A kutatás főbb eredményei:
- A baktériumok már az antibiotikumok széles körű alkalmazása előtt ellenállóvá, azaz rezisztenssé válhatnak, aláásva ezen gyógyszerek hatékonyságát.
- A rezisztenciát okozó mutációk gyakran már jelen vannak a természetben élő baktériumokban, valószínűleg a múltbéli antibiotikum-túlhasználat miatt.
- Az antibiotikum fejlesztési programok sikeressége jelentősen növelhető lenne, ha a rezisztencia kialakulását már a fejlesztés korai szakaszában figyelembe vennék.
A “rezisztencia-mentes” antibiotikumok mítosza
“Az új antibiotikumokat a fejlesztők gyakran úgy hirdetik, hogy nem alakul ki ellenük rezisztencia. Azonban ezt az állítást a rezisztencia-mentességről ritkán támasztják alá meggyőző adatok.” nyilatkozta Dr. Pál Csaba, akadémikus, a kutatások vezetője.
“A kutatásunk egy másik problémára is rávilágított: az antibiotikum fejlesztés általában arra irányul, hogy az adott szer minél több baktériumra hasson, azaz minél szélesebb legyen a spektruma. Való igaz, hogy sok új antibiotikum hatékonyabb ebből a szempontból az elődeinél, de ez egyáltalán nem garancia arra, hogy sokáig hatásos is marad a klinikumban.”
Elkeserítőek az eredmények
A két tanulmány összesen 18 új antibiotikumot vett górcső alá, és az eredmények meglehetősen elkeserítőek: szinte minden tesztelt antibiotikum ellen gyorsan kialakult a rezisztencia, megcáfolva a korábban leközölt ígéreteket.
Például, elsőként mutattak ki rezisztenciát a korábban csodagyógyszernek gondolt teixobaktin ellen, sőt, az erre a szerre ellenállóvá vált baktériumok más fontos antibiotikumokra is rezisztensek lettek. A helyzetet tovább súlyosbítja azon felfedezés. hogy a rezisztenciáért felelős mechanizmusok jelentős része már kimutatható klinikai izolátumokban, még mielőtt ezen baktériumok találkoztak volna az új szerekkel.
Ennek két valószínű oka lehet:
- 1 az egyik a meglévő antibiotikumok túlzott használata,
- 2 a másik pedig az a tény, hogy az új antibiotikumok gyakran nem is annyira “újak”, mivel az elődeikhez hasonló elven működnek.
Ez komoly veszélyforrást jelent, mivel így a legújabb antibiotikum jelöltek is hatástalanná válhatnak röviddel azután, hogy forgalomba kerülnek.
Változásra van szükség az antibiotikumok fejlesztésében
A kutatók szerint gyökeres szemléletváltásra van szükség az antibiotikum-fejlesztésben. A felelős cégeknek a fejlesztési folyamat kezdetétől be kellene építeni a lehetséges rezisztencia mechanizmusok átfogó vizsgálatát. Ezáltal csökkenhet a rezisztencia kialakulásának kockázata. Ez nem csak tudományos, hanem gazdasági szempontból is előnyös. Jelenleg ugyanis az antibiotikum-fejlesztések nagy része veszteséges, részben pont a rezisztencia korai felbukkanása miatt.
“Ki kell emelnünk, hogy néhány új antibiotikum viszont ígéretes a jövőre nézve. Ezekre lassabban alakul ki a rezisztencia, vagy csak bizonyos baktériumfajok képesek alkalmazkodni hozzájuk. A következő fontos lépés az, hogy minél jobban megértsük ezen ígéretes antibiotikumok közös jellemzőit.” – jegyezte meg Dr. Daruka Lejla, a tanulmányok egyik első szerzője.
Az új kutatási eredmények rávilágítanak arra, hogy az új antibiotikumok fejlesztésénél az innovatív megközelítéseket kellene előtérbe helyezni, beleértve az új célpontok kiaknázását illetve a már meglévők előnyös kombinálását. Emellett kiemelt fontosságú a már forgalomban lévő antibiotikumok felelős használata. Így a rezisztencia mechanizmusok terjedését lassíthatjuk, és ezáltal megőrizhetjük az új szerek hatékonyságát.

Katasztrofális jövőt jósolnak a rezisztens baktériumok: milyenek lesznek a jövő antibiotikumai?
Kövesse az Egészségkalauz cikkeit a Google Hírek-ben, a Facebook-on, az Instagramon vagy a X-en,Tiktok-on is!